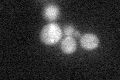
YHR144C
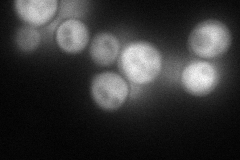
YHR144C
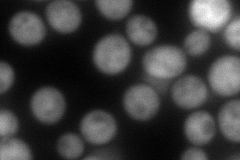
YHR144C
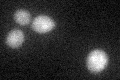
YHR144C

View description
Deoxycytidine monophosphate (dCMP) deaminase required for dCTP and dTTP synthesis; expression is NOT cell cycle regulated
Localization:
Intensity:
Fold change:
Significance:
-
C’ GFP library in SD
cytosol22.44 -
N' NOP1pr-GFP in SD
cytosol118.395 -
N' TEF2pr-mCherry in SD
cytosol157.252 -
N' NATIVEpr-GFP in SD

cytosol26.2148 -
N' TEF2pr-VC and Cyto-VN in SD

#N/A0 -
C’ GFP library in SD+DTT
cytosol20.110.89No -
C’ GFP library in SD+H2O2

cytosol20.960.93No -
C’ GFP library in Starvation Media

cytosol15.760.7No -
C’ GFP library on the background of Pup2-DaMP

cytosol -
C’ GFP library on the background of CCT mutant

cytosol20.77850.925876No
